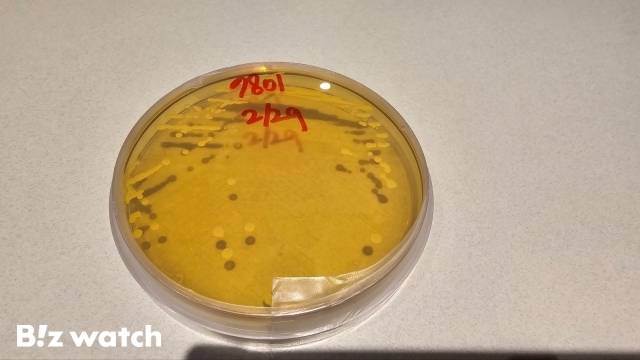
종균을 배양하는 모습 / 사진=김지우 기자 zuzu@

"장 넘어 신체를 이롭게"…hy의 '프로바이오틱스' 자신감
유산균·프로바이오틱스 차이점 소개
신체 기능성별 프로바이오틱스 연구 중

"장을 넘어 신체 전체를 이롭게 하는 연구를 하겠습니다."
국내 최초로 발효유를 개발한 hy가 신체기능별 프로바이오틱스를 개발에 박차를 가하고 있다. 그동안 프로바이오틱스 제품이 주로 장 건강에 집중돼 있었다면, 다양한 프로바이오틱스를 개발하겠다는 포부다.
6조 건기식 시장…알고 먹자
hy는 지난 19일 'hy 프로바이오틱스 클래스'를 열었다. 건강기능식품 시장이 성장하면서 프로바이오틱스에 대한 관심이 높아지자, 이를 보다 쉽게 이해할 수 있도록 돕기 위한 취지다. 실제로 국내 건강기능식품 시장 규모는 2022년 기준 6조원을 넘어섰다. 팬데믹 이전인 2019년에 비해 약 25% 성장했다. 건기식 중 프로바이오틱스 시장 규모는 8900억원에 달한다.
이날 정혁진 hy 유제품CM팀 책임연구원은 유산균과 프로바이오틱스의 개념을 설명했다. 그는 "프로바이오틱스는 인체에 이로움을 주는 모든 미생물을 총칭한다"며 "유산균은 탄수화물 당성분을 이용해 유산을 생산하는 미생물로, 프로바이오틱스는 인체에 좋은 유산균"이라고 말했다.
유산균을 비롯한 미생물들이 프로바이오틱스로 인정받기 위해서는 위와 쓸개를 거쳐 소장, 대장까지 도달해 증식, 정착할 수 있어야 한다. 또 장에서 유용한 효과를 내야 한다. 프로바이오틱스는 식품 등에서 종균을 추출 후 배양해 만들어진다. 이때 시럽을 조합하면 액상형이 되고, 동결 건조하면 분말형태가 된다.
국내 원조 프로바이오틱스
hy는 1971년 국내 최초의 발효유 '야쿠르트'를 개발한 회사다. 그런 만큼 프로바이오틱스에 대한 자부심을 갖고 있다. hy에 따르면 야쿠르트 한 병(65㎖)에는 200억마리 이상의 유산균이 들어있다. 마시는 형태와 떠먹는 형태의 농후 발효유에는 유산균수가 1억 마리 이상 포함돼 있다.
2021년에는 기존 분말 외에 액상 형태도 제조 가능하도록 규정이 변경되면서, 식약처로부터 국내 최초의 액상 프로바이오틱스로 인정받았다. 앞서 hy는 2020년 분말 형태의 프로바이오틱스를 B2B 사업으로 시작했다.

hy는 프로바이오틱스에 기능성을 더한 제품에 집중했다. 그 결과물이 △위 건강 '헬리코박터 프로젝트 윌' △간 건강 '쿠퍼스' △장 건강 이중제형 '엠프로' △멘탈케어 '쉼' 등이다. 이는 다양한 균주를 보유한 덕분이었다. hy는 5091종의 균주 라이브러리를 보유하고 있다. 균주를 활용해 기능성과 특성에 맞는 프로바이오틱스 제품을 만든다.
더불어 새로운 균주를 발굴하기 위해 중앙연구소 연구원들은 전국을 돌아다닌다. 5일장, 전통시장 등에 방문해 김치, 메주, 탁주 등에서 균주를 추출해 배양한다. hy는 액상 프로바이오틱스를 20일간 장기 배양한다. 균주를 일정 기간 배양한 후 새로운 배양 배지로 옮겨 다시 배양한다. 이를 통해 소화관 생존률과 장내 정착성이 높은 균주를 만들 수 있다는 설명이다.
또 hy는 분변의 장내 미생물 배양 연구를 진행하기 위해 '대장 모사시스템'을 운영 중이다. 사람을 대상으로 하기 어려운 부분을 인체 대장환경의 생화학적·미생물학적 특성을 비슷하게 만들어 연구하고 있다. 이를 통해 실시간 분변 마이크로바이옴의 변화를 추적할 수 있다는 설명이다.
신체 기능성별 프로바이오틱스 연구
hy는 장 건강을 넘어 다양한 신체 기능별 프로바이오틱스 개발에 힘쓰고 있다. △체지방 감소 △간 건강 △피부보습 △눈 건강 △장내환경 개선 △장관면역개선 △면역증강 △근력개선 △여성건강 △정신건강(스트레스) △호흡기 등의 기능성 프로바이오틱스를 선보이겠다는 목표다.

더불어 천연물의 기능이 몸에 잘 적용되도록 기능을 높여주는 균도 연구하고 있다. 약 250여 종의 천연물 라이브러리를 운영하며 고기능성 식품·건기식 소재를 발굴하고 있다. 발효홍삼 농축액에 들어있는 진세노사이드 성분의 크기를 작게 만드는 균을 개발해 인체에 흡수를 돕는 연구 등을 진행해왔다.
김주연 R&BD부문 미래성장센터 신소재개발팀 팀장은 "기능성 프로바이오틱스를 개발하는 데는 평균 5~6년이 걸린다"며 "프로바이오틱스가 장에 좋은 것은 많이 알려져 있지만, 신체 기능별 이롭게 하는 프로바이오틱스를 연구 개발해 세계 수준의 K-프로바이오틱스를 만드는 것이 목표"라고 말했다.
김지우 (zuzu@bizwatch.co.kr)
ⓒ비즈니스워치의 소중한 저작물입니다. 무단전재와 재배포를 금합니다.
Copyright © 비즈워치. 무단전재 및 재배포 금지.
- 코인거래소 한도해제 제각각…"시장혼탁 우려"
- "3기신도시 땅 풀린다"…LH 올해 65필지 매각
- [공모주달력]이노그리드 증권신고서 정정으로 청약 연기
- 남양유업, 홍원식 회장 '버티기' 끝…'한앤코 체제' 시작
- 알테오젠, 기술수출 800억 넘었다...꽃길 걸은 비결
- 머스크 등 세계적 선사들, 부산 '패싱'…부산항만공사 '고심'
- '엔화 노출 미국채 ETF' 격돌…KB vs 한투 어디가 낫나
- '수족구 보험금 100만원'…돌연 판매중단한 메리츠화재 왜?
- 2030년까지 기후위기 대응에 정책금융 420조 투입
- [청기홍기]SK하이닉스, '엔비디아와 함께'…목표주가 줄줄이↑